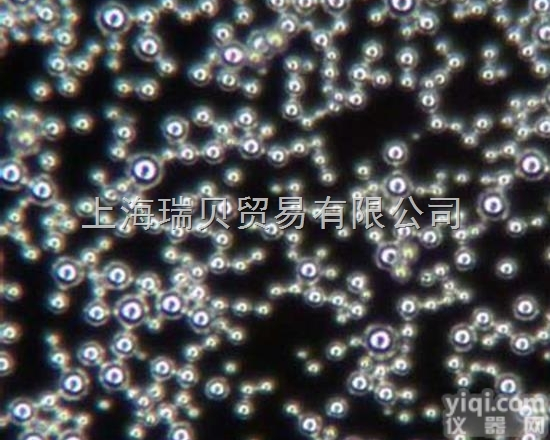
供应美国杜克DUKE镀镍（<em>导电</em>）<em>玻璃</em>微球

实验室用FTO导电玻璃
FTO导电玻璃为掺杂氟的氧化锡SnO2透明导电玻璃(SnO2:F),简称FTO。FTO玻璃被作为ITO导电玻璃的替代用品被开发利用,可被广泛用于液晶显示屏、光催化、薄膜太阳能电池基底、燃料敏化太阳能电池、电致变色玻璃等领域。Z近,随着钙钛矿太阳能电池取得突破性的进展,FTO导电玻璃因其优异的耐高温性能成为目前钙钛矿太阳能电池透明电极材料。
本公司专业生产销售ITO,FTO,AZO导电玻璃,各种试验室产品刻蚀服务,可按您的要求订做,您想要的产品!
主要适用对象:大学试验室,研究院;适用范围:太阳能电池, 电极,电化学沉积, 红外线测试,LCD显示屏,电容屏,屏障材料,电加热除霜等!
常规电阻:6欧,10欧,15欧, 30欧,300欧,非常规电阻:8欧,300欧,玻璃厚度:0.4mm,0.55mm, 0.7mm, 1.1mm, 1.8mm, 2.2mm ,3.2mm 规格都可您要求切割。
如果您对我发布的《洛阳腾昌旭坤生物科技有限公司》的内容和产品感兴趣,请联系我们,并告诉我您是在本网站上看到我们发布的产品,我们会给你报价并详细地介绍产品,谢谢。
资料下载:
10FTO玻璃1.jpg
附件下载 (下载 0 次)
请 [登录] 后再下载!